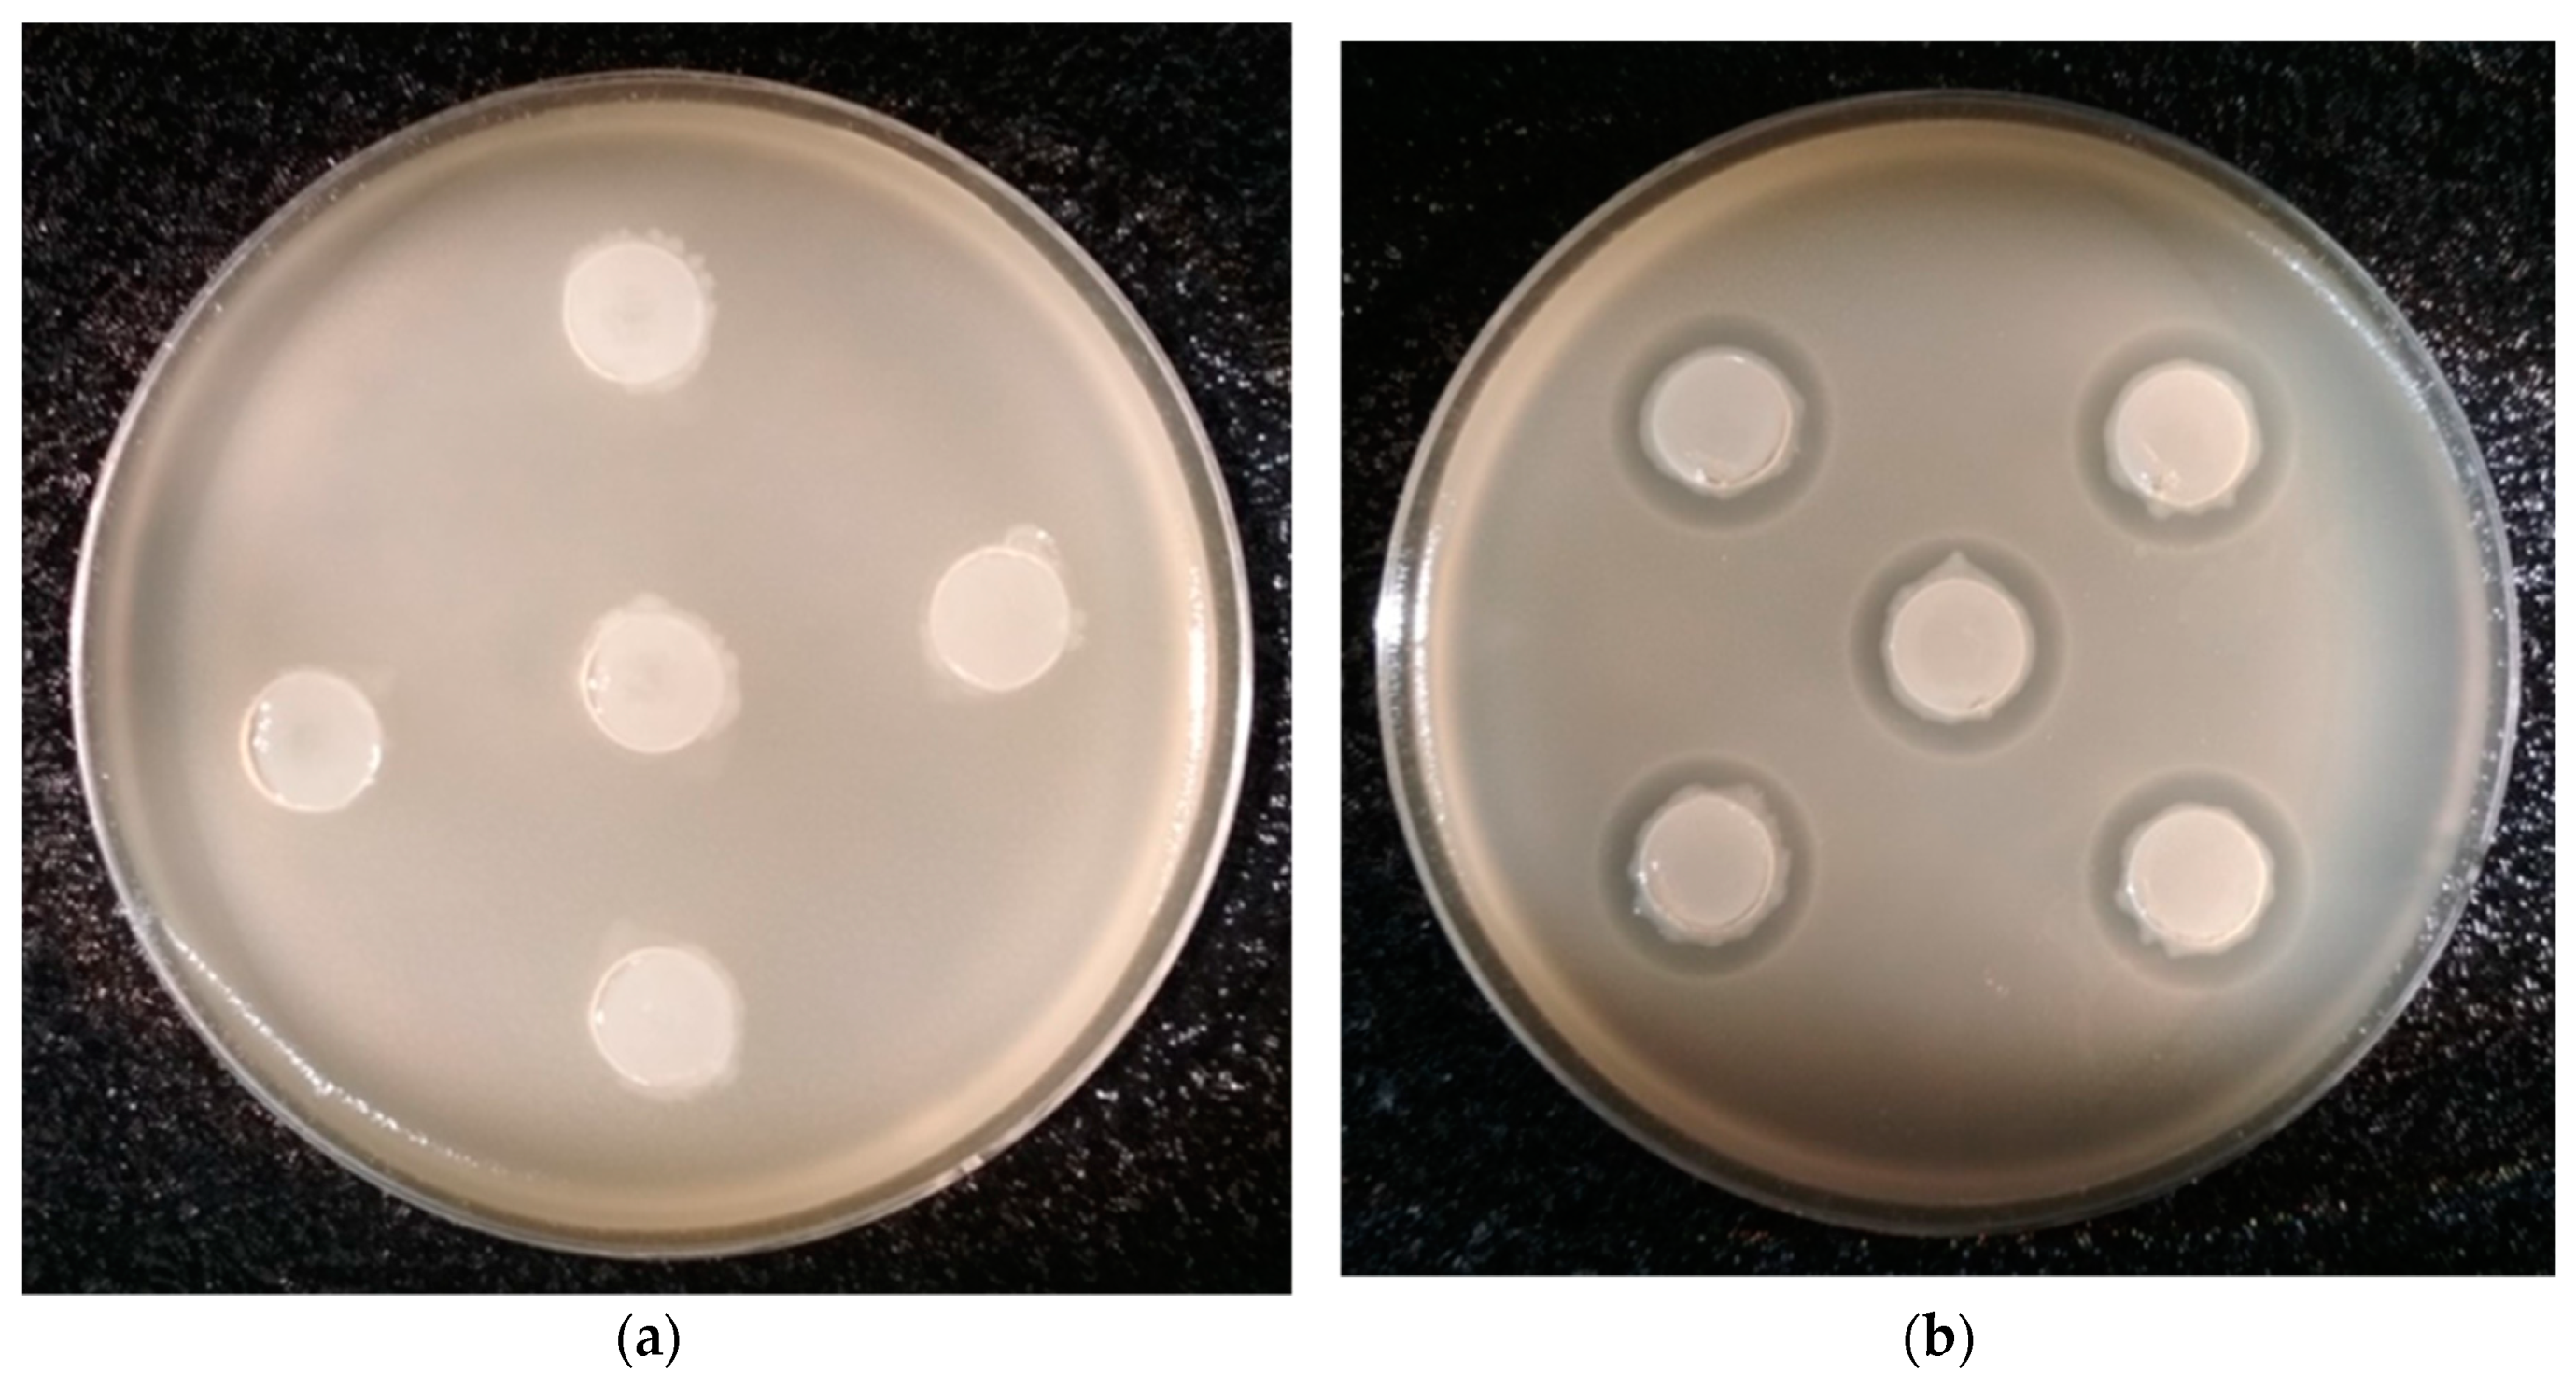

Bacteria from the Midgut of Common Cockchafer (Melolontha melolontha L.) Larvae Exhibiting Antagonistic Activity Against Bacterial Symbionts of Entomopathogenic Nematodes: Isolation and Molecular Identification
Abstract
1. Introduction
2. Results
2.1. Isolation of Bacteria from the Midgut of M. melolontha Larvae
2.2. Screening of Midgut Bacteria with Antagonistic Activity Against EPB
2.3. Identification of Selected Midgut Isolates from M. melolontha Larvae
2.4. Detailed Evaluation of Antibacterial Activity of Selected Gut Isolates from M. melolontha Larvae
3. Discussion
4. Materials and Methods
4.1. Entomopathogenic Nematodes
4.2. Entomopathogenic Nematodes Symbiotic Bacteria
4.3. Collection of M. melolontha Larvae from Their Natural Environment
4.4. Exposure of M. melolontha to Selected EPN Species
4.5. Isolation of Bacteria from M. melolontha Midgut
4.6. Antimicrobial Activity Assays
4.6.1. Cross-Streak Tests
4.6.2. Modified Agar Well Diffusion Tests
4.6.3. Maximum Inhibitory Dilution (MID) Tests
4.7. Molecular Identification of the Bacterial Isolates
4.8. Phylogenetic Analysis
4.9. Statistical Analysis
Supplementary Materials
Author Contributions
Funding
Acknowledgments
Conflicts of Interest
Abbreviations
| ANOVA | Analysis of variance |
| BLAST | Basic local alignment search tool |
| EPB | Entomopathogenic bacteria |
| EPN | Entomopathogenic nematodes |
| IJs | Infective juveniles |
| LB | Lysogeny broth (or Luria broth) |
| MID | Maximum inhibitory dilution |
| NBTA | Nutrient bromothymol blue agar |
| NCBI | National Center for Biotechnology Information |
| PCR | Polymerase chain reaction |
References
- Jameson, M.L.; Ratcliffe, B.C. Introduction. Series Scarabaeiformia Crowson 1960 (Lamellicornia), Superfamily Scarabaeoidea Latreille 1802. In American Beetles. Polyphaga: Scarabaeoidea through Curculionoidea; Arnett, R.H., Thomas, M.C., Skelley, P.E., Frank, J.H., Eds.; CRC Press: New York, NY, USA, 2002; Volume 2, pp. 1–5. [Google Scholar]
- Zimmermann, G. Use of the fungus, Beauveria brongniartii for the control of European cockchafers, Melolontha spp. In Europe. In Use of Pathogens in Scarab Pest Management; Jackson, T.A., Glare, T.R., Eds.; Andover, Hampshire: Intercept, UK, 1992; pp. 199–208. [Google Scholar]
- Jackson, T.A.; Klein, M.G. Scarabs as pests: A continuing problem. Coleopt. Soc. Monogr. 2006, 5, 102–119. [Google Scholar] [CrossRef]
- Ansari, M.A.; Shah, F.A.; Tirry, L.; Moens, M. Field trials against Hoplia philanthus (Coleoptera: Scarabaeidae) with a combination of an entomopathogenic nematode and the fungus Metarhizium anisopliae CLO 53. Biol. Control 2006, 39, 453–459. [Google Scholar] [CrossRef]
- Kaya, H.K.; Aguillera, M.M.; Alumai, A.; Choo, H.Y.; de la Torre, M.; Fodor, A.; Ganguly, S.; Hazir, S.; Lakatos, T.; Pye, A.; et al. Status of entomopathogenic nematodes and their symbiotic bacteria from selected countries or regions of the world. Biol. Control 2006, 38, 134–155. [Google Scholar] [CrossRef]
- Lacey, L.; Georgis, R. Entomopathogenic nematodes for control of insect pests above and below ground with comments on commercial production. J. Nematol. 2012, 44, 218–225. [Google Scholar] [PubMed]
- Akhurst, R.J. Safety to nontarget invertebrates of nematodes of economically important pests. In Safety of Microbial Insecticides; Laird, M., Lacey, L.A., Davidson, E.W., Eds.; CRC Press: Boca Raton, FL, USA, 1990; pp. 234–238. [Google Scholar]
- Wilson, M.; Gaugler, R. Terrestrial slug pests. In Field Manual for Application and Evaluation of Invertebrate Pathogens; Lacey, L., Kaya, H., Eds.; Kluwer Academic Publishers: Dordrecht, The Netherlands, 2000; pp. 784–804. [Google Scholar]
- An, R.; Grewal, P.S. Differences in the virulence of Heterorhabditis bacteriophora and Steinernema scarabaei to three white grub species: The relative contribution of the nematodes and their symbiotic bacteria. Biol. Control 2007, 43, 310–316. [Google Scholar] [CrossRef]
- Beliën, T. Entomopathogenic nematodes as biocontrol agents of insect pests in orchards. CAB Rev. 2018, 13, 1–11. [Google Scholar] [CrossRef]
- Marianelli, L.; Paoli, F.; Torrini, G.; Mazza, G.; Benvenuti, C.; Binazzi, F.; Sabbatini Peverieri, G.; Bosio, G.; Venanzio, D.; Giacometto, E.; et al. Entomopathogenic nematodes as potential biological control agents of Popillia japonica (Coleoptera, Scarabaeidae) in Piedmont Region (Italy). J. Appl. Entomol. 2017, 142, 311–318. [Google Scholar] [CrossRef]
- Polavarapu, S.; Koppenhöfer, A.M.; Barry, J.D.; Holdcraft, R.J.; Fuzy, E.M. Entomopathogenic nematodes and neonicotinoids for remedial control of oriental beetle, Anomala orientalis (Coleoptera: Scarabaeidae), in highbush blueberry. Crop Prot. 2007, 26, 1266–1271. [Google Scholar] [CrossRef]
- Boemare, N.E. Biology, Taxonomy and Systematics of Photorhabdus and Xenorhabdus. In Entomopathogenic Nematology; Gaugler, R., Ed.; CABI Publishing: New York, NY, USA, 2002; pp. 35–56. [Google Scholar] [CrossRef]
- Gaugler, R. Ecological consideration in the biological control of soil-Habitating insect with entomopathogenic nematode. Agr. Ecosyst. Environ. 1988, 24, 351–360. [Google Scholar] [CrossRef]
- Gaugler, R.; Kaya, H.K. Entomophathogenic Nematodes in Biological Control; CRC Press: Boca Raton, FL, USA, 1990. [Google Scholar]
- Adams, B.J.; Fodor, A.; Koppenhofer, H.S.; Stackebrandt, E.; Stock, S.P.; Klein, M.G. Reprint of “Biodiversity and systematics of nematode-Bacterium entomopathogens”. Biol. Control 2006, 38, 4–21. [Google Scholar] [CrossRef]
- Akhurst, R.J. Antibiotic activity of Xenohabdus spp., bacteria symbiotically associated with insect pathogenic nematodes of the families Heterorhabditidae and Steinernematidae. J. Gen. Microbiol. 1982, 128, 3061–3065. [Google Scholar] [PubMed]
- Boemare, N.E.; Givaudan, A.; Brehelin, M.; Laumond, C. Symbiosis and pathogenicity of nematode-Bacterium complexes. Symbiosys 1997, 22, 21–45. [Google Scholar]
- Nguyen, K.B.; Hunt, D.J. Entomopathogenic Nematodes: Systematics, Phylogeny and Bacterial Symbionts; Brill: Leiden, The Netherlands, 2007. [Google Scholar]
- Huang, S.-W.; Zhang, H.-Y.; Marshall, S.; Jackson, E.A. The scarab gut: A potential bioreactor for bio-Fuel production. Insect Sci. 2010, 17, 175–183. [Google Scholar] [CrossRef]
- Miller, C.S.; Handley, K.M.; Wrighton, K.C.; Frischkorn, K.R.; Thomas, B.C.; Banfield, J.F. Short-Read assembly of full-Length 16S amplicons reveals bacterial diversity in subsurface sediments. PLoS ONE 2013, 8, e56018. [Google Scholar] [CrossRef] [PubMed]
- Rajwar, A.; Sahgal, M. Phylogenetic relationships of fluorescent pseudomonas deduced from the sequence analysis of 16S rRNA, Pseudomonas-Specific and rpoD genes. 3 Biotech. 2016, 6, 80. [Google Scholar] [CrossRef] [PubMed]
- Delétoile, A.; Decré, D.; Courant, S.; Passet, V.; Audo, J.; Grimont, P.; Arlet, G.; Brisse, S. Phylogeny and identification of Pantoea species and typing of Pantoea agglomerans strains by multilocus gene sequencing. J. Clin. Microbiol. 2009, 47, 300–310. [Google Scholar] [CrossRef] [PubMed]
- Khosravi, A.D.; Sadeghi, P.; Shahraki, A.H.; Heidarieh, P.; Sheikhi, N. Molecular methods for identification of Acinetobacter species by partial sequencing of the rpoB and 16S rRNA Genes. J. Clin. Diagn. Res. 2015, 9, DC09–DC13. [Google Scholar] [CrossRef]
- Whitehouse, C.A.; Baldwin, C.; Wasieloski, L.; Kondig, J.; Scherer, J. Molecular identification of the biowarfare simulant Serratia marcescens from a 50-Year-Old munition buried at Fort Detrick, Maryland. Mil. Med. 2007, 172, 860–863. [Google Scholar] [CrossRef]
- Hilario, E.; Buckley, T.R.; Young, J.M. Improved resolution on the phylogenetic relationships among Pseudomonas by the combined analysis of atpD, carA, recA and 16S rDNA. Antonie Van Leeuwenhoek 2004, 86, 51–64. [Google Scholar] [CrossRef]
- Thaler, J.O.; Baghdiguian, S.; Boemare, N. Purification and characterization of xenorhabdicin, a phage tail-Like bacteriocin, from the lysogenic strain F1 of Xenorhabdus nematophilus. Appl. Environ. Microb. 1995, 61, 2049–2052. [Google Scholar] [CrossRef]
- Ffrench-Constant, R.; Waterfield, N.; Daborn, P.; Joyce, S.; Bennett, H.; Au, C.; Dowling, A.; Boundy, S.; Reynolds, S.; Clarke, D. Photorhabdus: Towards a functional genomic analysis of a symbiont and pathogen. Fems Microbiol. Rev. 2003, 26, 433–456. [Google Scholar] [CrossRef] [PubMed]
- Sharma, S.; Waterfield, N.; Bowen, D.; Rocheleau, T.; Holland, L.; James, R.; Ffrench-Constant, R. The lumicins: Novel bacteriocins from Photorhabdus luminescens with similarity to the uropathogenic-Specific protein (USP) from uropathogenic Escherichia coli. Fems Microbiol. Lett. 2002, 214, 241–249. [Google Scholar] [CrossRef] [PubMed]
- Hu, K.; Webster, J.M. Antibiotic production in relation to bacterial growth and nematode development in Photorhabdus heterorhabditis infected Galleria mellonella larvae. Fems Microbiol. Lett. 2000, 189, 219–223. [Google Scholar] [CrossRef]
- White, J.F.; Torres, M.S. Defensive Mutualism in Microbial Symbiosis; CRC Press: Boca Raton, FL, USA, 2009. [Google Scholar]
- Isaacson, P.J.; Webster, J.M. Antimicrobial activity of Xenorhabus sp RIO (Enterobacteriaceae), symbiont of the entomopathogenic nematode, Steinernema riobrave (Rhabditida: Steinernematidae). J. Invertebr. Pathol. 2002, 79, 146–153. [Google Scholar] [CrossRef]
- Walsh, K.T.; Webster, J.M. Interaction of microbial populations in Steinernema (Steinernematidae, Nematoda) infected Galleria mellonella larvae. J. Invertebr. Pathol. 2003, 83, 118–126. [Google Scholar] [CrossRef]
- Stackebrandt, E.; Ebers, J. Taxonomic parameters revised: Tarnished gold standards. Microbiol. Today 2006, 33, 152–155. [Google Scholar]
- Rossi-Tamisier, M.; Benamar, S.; Raoult, D.; Fournier, P.E. Cautionary tale of using 16S rRNA gene sequence similarity values in identification of human-Associated bacterial species. Int. J. Syst. Evol. Microbiol. 2015, 65, 1929–1934. [Google Scholar] [CrossRef]
- Yarza, P.; Yilmaz, P.; Pruesse, E.; Glöckner, F.O.; Ludwig, W.; Schleifer, K.-H.; Whitman, W.B.; Euzéb, J.; Amann, R.; Rosselló-Móra, R. Uniting the classification of cultured and uncultured bacteria and archaea using 16S rRNA gene sequences. Nat. Rev. Microbiol. 2014, 12, 635–645. [Google Scholar] [CrossRef]
- Arias-Cordero, E.; Ping, L.; Reichwald, K.; Delb, H.; Platzer, M.; Boland, W. Comparative evaluation of the gut microbiota associated with the below- and above-Ground life stages (larvae and beetles) of the forest cockchafer, Melolontha hippocastani. PLoS ONE 2012, 7, e51557. [Google Scholar] [CrossRef]
- Huang, S.; Sheng, P.; Zhang, H. Isolation and identification of cellulolytic bacteria from the gut of Holotrichia parallela larvae. Int. J. Mol. Sci. 2012, 13, 2563–2577. [Google Scholar] [CrossRef]
- Tian, X.-Y.; Song, F.-P.; Zhang, J.; Liu, R.-M.; Zhang, X.-P.; Duan, J.-Y.; Shu, C.-L. Diversity of gut bacteria in larval Protaetia brevitarsis (Coleoptera: Scarabaedia) fed on corn stalk. Acta Entomol. Sin. 2017, 60, 632–641. [Google Scholar]
- Deng, P.; Wang, X.; Baird, S.M.; Lu, S.E. Complete genome of Pseudomonas chlororaphis strain UFB2, a soil bacterium with antibacterial activity against bacterial canker pathogen of tomato. Stand. Genom. Sci. 2015, 10, e117. [Google Scholar] [CrossRef] [PubMed]
- Aichour, S.M.; Nicklin, J.L.; Haichour, N.; Zerroug, M.M. Antimicrobial activity of potato rhizospheric Pseudomonas chlororaphis subsp. aureofaciens from Sétif Algeria. Ann. Res. Rev. Biol. 2016, 11, 1–7. [Google Scholar] [CrossRef]
- Veselova, A.; Klein, S.H.; Bass, I.A.; Lipasova, V.A.; Metlitskaya, A.Z.; Ovadis, M.I.; Chernin, L.S.; Khmel, I.A. Quorum sensing systems of regulation, synthesis of phenazine antibiotics, and antifungal activity in rhizospheric bacterium Pseudomonas chlororaphis 449. Russ. J. Genet. 2008, 44, 1400–1408. [Google Scholar] [CrossRef]
- Urgas, S.; Sezen, K.; Kati, H.; Demirbag, Z. Purification and characterization of an antibacterial substance produced by pest-Originated Serratia marcescens Mm3. Turk. J. Biol. 2014, 38, 177–184. [Google Scholar] [CrossRef]
- Sezen, K.; Demir, Ŷ.; Demirbağ, Z. Identification and pathogenicity of entomopathogenic bacteria from common cockchafer, Melolontha melolontha (Coleoptera: Scarabaeidae). N. Z. J. Crop. Hort. 2007, 35, 79–85. [Google Scholar] [CrossRef]
- Lee, J.; Hwang, S.; Cho, S. Immune tolerance to an intestine-adapted bacteria, Chryseobacterium sp., injected into the hemocoel of Protaetia brevitarsis seulensis. Sci. Rep. UK 2016, 6, 31722. [Google Scholar] [CrossRef]
- Shanks, R.M.Q.; Dashiff, A.; Alster, J.S.; Kadouri, D.E. Isolation and identification of a bacteriocin with antibacterial and antibiofilm activity from Citrobacter freundii. Arch. Microbiol. 2012, 194, 575–587. [Google Scholar] [CrossRef]
- Mandal, S.M.; Sharma, S.; Pinnaka, A.K.; Kumari, A.; Korpole, S. Isolation and characterization of diverse antimicrobial lipopeptides produced by Citrobacter and Enterobacter. BMC Microbiol. 2013, 13, e152. [Google Scholar] [CrossRef]
- Nam, H.S.; Anderson, A.J.; Kim, Y.C. Biocontrol efficacy of formulated Pseudomonas chlororaphis O6 against plant diseases and root-Knot nematodes. Plant Pathol. J. 2018, 34, 241–249. [Google Scholar] [CrossRef]
- Anderson, J.A.; Staley, J.; Challender, M.; Heuton, J. Safety of Pseudomonas chlororaphis as a gene source for genetically modified crops. Transgenic Res. 2018, 27, 103–113. [Google Scholar] [CrossRef] [PubMed]
- Flury, P.; Vesga, P.; Pechy-Tarr, M.; Aellen, N.; Dennert, F.; Hofer, N.; Kupferschmied, K.P.; Kupferschmied, P.; Melta, Z.; Ma, Z.; et al. Antimicrobial and insecticidal: Cyclic lipopeptides and hydrogen cyanide produced by plant-Beneficial Pseudomonas strains CHA0, CMR12a, and PCL1391 contribute to insect killing. Front. Microbiol. 2017, 8, 100. [Google Scholar] [CrossRef] [PubMed]
- Rangel, L.I.; Henkels, M.D.; Shaffer, B.T.; Walker, F.L.; Davis II, E.W.; Stockwell, V.O.; Bruck, D.; Taylor, B.J.; Loper, J.E. Characterization of toxin complex gene clusters and insect toxicity of bacteria representing four subgroups of Pseudomonas fluorescens. PLoS ONE 2016, 11, e0161120. [Google Scholar] [CrossRef]
- Schellenberger, U.; Oral, J.; Rosen, B.A.; Wei, J.Z.; Xie, W.; McDonald, M.J.; Cerf, D.C.; Diehn, S.H.; Crane, V.C.; Sandhal, G.A.; et al. A selective insecticidal protein from Pseudomonas for controlling corn rootworms. Science 2016, 354, 634–637. [Google Scholar] [CrossRef] [PubMed]
- Ertürk, Ö.; Yaman, M. Potential of five non-Spore-Forming bacteria, originated from the European cockchafer, Melolontha melolontha (Linnaeus, 1758) (Coleoptera: Scarabaeidae), on three economic insect pests. Egypt. J. Biol. Pest Control 2019, 29, 59. [Google Scholar] [CrossRef]
- Aryal, S.K.; Carter-House, D.; Stajich, J.E.; Dillman, A.R. Microbial associates of the southern mole cricket (Scapteriscus borellii) are highly pathogenic. J. Invertebr. Pathol. 2017, 150, 54–62. [Google Scholar] [CrossRef]
- White, G. A method for obtaining infective nematode larvae from culture. Science 1927, 66, 302–303. [Google Scholar] [CrossRef]
- Tamura, K.; Stecher, G.; Peterson, D.; Filipski, A.; Kumar, S. MEGA6: Molecular evolutionary genetics analysis version 6.0. Mol. Biol. Evol. 2013, 30, 2725–2729. [Google Scholar] [CrossRef]

| Strain ID * | Size of Inhibition Zones (mm) Left Inhibition Zone|Right Inhibition Zone | ||||
|---|---|---|---|---|---|
| P. temperata | X. kozodoii | X. bovienii | X. nematophila | X. budapestensis | |
| MT1 L2 01 | 0|0 | 12|13 | 20|18 | no gr. **| no gr. | no gr.|no gr. |
| MT1 L2 02 | 1|1 | 1|1 | no gr.|no gr. | no gr.|no gr. | 7|4 |
| MT3 L2 02 | 2|4 | no gr.|no gr. | no gr.|no gr. | no gr.|no gr. | no gr.|no gr. |
| MT3 L2 05 | 12|7 | no gr.|no gr. | no gr.|no gr. | no gr.|no gr. | no gr.|no gr. |
| MT3 L2 06 | 6|6 | no gr.|no gr. | no gr.|no gr. | no gr.|no gr. | no gr.|no gr. |
| MT3 L2 08 | 10|12 | no gr.|no gr. | no gr.|no gr. | no gr.|no gr. | no gr.|no gr. |
| MT3 L2 10 | 12|11 | no gr.|no gr. | no gr.|no gr. | no gr.|no gr. | no gr.|no gr. |
| MT3 L2 13 | 7|5 | no gr.|no gr. | no gr.|no gr. | no gr.|no gr. | no gr.|no gr. |
| MT4 L2 11 | 0|0 | 0|0 | 30|22 | no gr.|24 | 18|no gr. |
| MTA1 L2 01 | 1|1 | no gr.|no gr. | no gr.|12 | 6|6 | 30|20 |
| MTA3 L2 13 | 5|5 | 25|25 | no gr.|no gr. | no gr.|no gr. | no gr.|no gr. |
| MTA5 L3 10 | 3|5 | 7|5 | no gr.|no gr. | no gr.|no gr. | 20|25 |
| MMB2 L3 03 | 0|0 | 0|1 | 11|12 | 4|0 | 3|3 |
| MMB2 L3 04 | 0|0 | 0|0 | 7|6 | 0|0 | 1| 0 |
| MMB2 L3 07 | 0|0 | 0|0 | 12|12 | 9|10 | 10|9 |
| MMB4 L3 10 | 0|0 | 0|0 | 11|12 | 1|0 | 0|0 |
| MTB1 L3 08 | 0|0 | 15|14 | no gr.|no gr. | no gr.|no gr. | no gr.|no gr. |
| MTB1 L3 09 | 0|0 | 15|20 | no gr.|no gr. | no gr.|no gr. | no gr.|no gr. |
| MTB1 L3 12 | 0|0 | no gr.|no gr. | no gr.|no gr. | no gr.|no gr. | no gr.|no gr. |
| MTB5 L3 11 | 0|0 | 7|10 | no gr.|no gr. | no gr.|no gr. | 17|22 |
| MMC3 L3 03 | 0|0 | 11|12 | 14|16 | 14|13 | 12|13 |
| MMC3 L3 04 | 0|0 | 11|13 | 15|17 | 15|17 | 15|14 |
| MMC3 L3 07 | 0|0 | 13|14 | 16|18 | 17|19 | 17|17 |
| MMC3 L3 12 | 0|0 | 12|14 | 15|17 | 15|16 | 15|14 |
| MTC1 L3 03 | 0|0 | 10|10 | no gr.|no gr. | no gr.|no gr. | no gr.|no gr. |
| MTS3 L3 15 | 8|7 | 25|25 | no gr.|no gr. | no gr.|no gr. | no gr.|no gr. |
| MMH3 L2 04 | 2|2 | 3|2 | 17|18 | 17|16 | 13|14 |
| MMH3 L2 05 | 2|1 | 3|2 | 14|16 | 12|15 | 12|10 |
| MMH3 L2 06 | 2|1 | 4|3 | 16|17 | 16|15 | 11|13 |
| MMH4 L2 06 | 1|1 | 2|3 | 17|15 | 10|13 | 9 |12 |
| MMH4 L2 07 | 1|1 | 2|2 | 14|13 | 12|10 | 12|11 |
| MMH5 L2 04 | 0|1 | 2|3 | 2|3 | 1|1 | 7|5 |
| MMH5 L2 08 | 0|0 | 0|0 | 4|4 | 5|5 | 3|3 |
| MTH3 L2 08 | 0|0 | 16|14 | no gr.|no gr. | no gr.|no gr. | no gr.|no gr. |
| MTH3 L2 09 | 0|0 | 10|9 | no gr.|no gr. | no gr.|no gr. | no gr.|no gr. |
| MTH3 L2 10 | 0|0 | 10|10 | no gr.|no gr. | no gr.|no gr. | no gr.|no gr. |
| MTH3 L2 14 | 0|0 | 14|15 | no gr.|no gr. | no gr.|no gr. | no gr.|no gr. |
| MTH3 L2 15 | 0|0 | 10|10 | no gr.|no gr. | no gr.|no gr. | no gr.|no gr. |
| Strain ID | Diameter of the Inhibition Zone (mm) | ||||
|---|---|---|---|---|---|
| P. temperata | X. kozodoii | X. bovienii | X. nematophila | X. budapestensis | |
| MT3 L2 05 | 0.00 | 0.00 | 14.00 ± 0.41 | 15.85 ± 0.41 | 15.35 ± 0.58 |
| MT3 L2 08 | 14.10 ± 0.46 | 16.95 ± 0.64 | 0.00 | 17.05 ± 0.55 | 17.45 ± 0.55 |
| MT3 L2 10 | 15.00 ± 0.33 | 18.55 ± 0.64 | 0.00 | 18.05 ± 0.64 | 17.05 ± 0.50 |
| MT3 L2 13 | 0.00 | 0.00 | 14.00 ± 0.58 | 16.05 ± 0.28 | 14.95 ± 0.44 |
| MTA1 L2 01 | 13.9 ± 0.66 | 0.00 | 15.05 ± 0.59 | 14.45 ± 0.39 | 0.00 |
| MTA3 L2 13 | 0.00 | 0.00 | 0.00 | 0.00 | 19.20 ± 0.48 |
| MTB1 L3 12 | 0.00 | 17.10 ± 0.57 | 0.00 | 0.00 | 18.05 ± 0.28 |
| MTC1 L3 03 | 0.00 | 0.00 | 0.00 | 0.00 | 19.25 ± 0.63 |
| MMC3 L3 04 | 16.00 ± 0.41 | 18.95 ± 0.60 | 16.10 ± 0.39 | 16.15 ± 0.34 | 19.90 ± 0.70 |
| MMH3 L2 04 | 0.00 | 16.05 ± 0.44 | 15.40 ± 0.32 | 17.05 ± 0.37 | 17.45 ± 0.39 |
| MMH4 L2 06 | 0.00 | 15.50 ± 0.52 | 0.00 | 17.00 ± 0.58 | 16.45 ± 0.55 |
| MTS3 L3 15 | 0.00 | 17.95 ± 0.68 | 14.05 ± 0.37 | 18.45 ± 0.44 | 16.10 ± 0.57 |
| Primer | Sequence | Target Gene | Target Bacterial Genus | PCR Cycling | Product Length | Reference |
|---|---|---|---|---|---|---|
| 27F 1492R | 5′-AGAGTTTGATCCTGGCTCAG-3′ 5′-GGTTACCTTGTTACGACTT-3′ | 16S rDNA | All tested | 3 min 95 °C, 30 × (30 s 94 °C, 45 s 55 °C, 90 s 72 °C), 5 min 72 °C | 1500 bp | [21] |
| PsEG30F PsEG790R | 5′- ATYGAA ATCGCCAARCG-3′ 5′-CGGTTGATKT CCTTGA-3′ | rpoD | Pseudomonas | 3 min 95 °C, 30 × (60 s 94 °C, 45 s 55 °C, 50 s 72 °C), 5 min 72 °C | 750 bp | [22] |
| Vic3 Vic2 | 5′-GGCGAAATGGCWGAGAACCA-3′ 5′-GAGTCTTCGAAGTTGTAACC-3′ | rpoB | Citrobacter | 4 min 94 °C, 30 × (30 s 94 °C, 30 s 50 °C, 45 s 72 °C), 5 min 72 °C | 410 bp | [23] |
| Ac696F Ac1093R | 5′-TAYCGYAAAGAYTTGAAAGAAG-3′ 5′-CMACACCYTTGTTMCCRTGA-3′ | rpoB | Acinetobacter | 3 min 95 °C, 30 × (60 s 94 °C, 52 s 45 °C, 60 s 72 °C), 5 min 72 °C | 370 bp | [24] |
| 359f 359r | 5′-TTATCGCTCAGGCGAACTCCAAC-3′ 5′-TGCTGGATTCGCCTTTGCTACG-3′ | rpoB | Serratia | 3 min 95 °C, 30 × (50 s 94 °C, 40 s 52 °C, 60s 72 °C), 5 min 72 °C | 530 bp | [25] |
| ESchr-rpoF ESchr-rpoR | 5′GGTGAAGTAGTTTCTATCGAAAGA-3′ 5′-ATGTTTGGTCCTTCCGGAGTT-3′ | rpoB | Chryseobacterium | 3 min 95 °C, 30 × (35 s 95 °C, 35 s 52 °C, 50 s 72 °C), 5 min 72 °C | 790 bp | This work |
| recAF recAR | 5′-TCSGGYAARACCACSCTGAC-3′ 5′-RTACCAGGCRCCGGACTTCT-3′ | recA | Pseudomonas | 4 min 94 °C, 30 × (30 s 94 °C, 30 s 55 °C, 40 s 72 °C), 5 min 72 °C | 600 bp | [26] |
| Strain ID | Identification Result/Gene Accession Numbers | Strain with the Highest Similarity to the Isolate in the Gene Bank Based on the Gene Sequence/Gene Accession Number/% Nucleotide Identity | ||
|---|---|---|---|---|
| 16S rDNA | rpoD/rpoB | recA | ||
| MT3 L2 05 | Pseudomonas chlororaphis 16S rDNA—MM421924 rpoD—MN445046 | P. chlororaphis subsp. piscum JF3835T (FJ168539)—99.8% | * P. chlororaphis subsp. piscum ZJU60 (CP027656)—98.2%; P. chlororaphis subsp. aurefaciens NCIMB 9265 (AB039555)—98.2% | n.d. |
| MT3 L2 08 | Pseudomonas chlororaphis 16S rDNA—MM421925 rpoD—MN445047 | P. chlororaphis subsp. piscum JF3835T (FJ168539)—99.8% | * P. chlororaphis subsp. piscum ZJU60 (CP027656)—98.2%; P. chlororaphis subsp. aurefaciens NCIMB 9265 (AB039555)—98.2% | n.d. |
| MT3 L2 10 | Pseudomonas chlororaphis 16S rDNA—MM421926 rpoD—MN445048 recA—MN477250 | P. chlororaphis subsp. piscum JF3835T (FJ168539)—99.8% | * P. chlororaphis subsp. piscum ZJU60 (CP027656)—98.0%; P. chlororaphis subsp. aurefaciens NCIMB 9265 (AB039555)—98.0% | P. chlororaphis subsp. piscum JF3835T (FJ168540)—98.4% |
| MT3 L2 13 | Pseudomonas chlororaphis 16S rDNA—MM421923 rpoD—MN445049 | P. chlororaphis subsp. piscum JF3835T (FJ168539)—99.9% | * P. chlororaphis subsp. piscum ZJU60 (CP027656)—98.0%; P. chlororaphis subsp. aurefaciens NCIMB 9265 (AB039555)—98.0% | n.d. |
| MTA1 L2 01 | Citrobacter murlinae 16S rDNA—MM421947 rpoB—MN445055 | C. murliniae CIP 104556T (KY178281)—99.3% | ** C. murliniae CIP 104556T (KM516007)—99.5% | n.d. |
| MMC3 L3 04 | Pseudomonas chlororaphis 16S rDNA—MM421927 rpoD—MN445050 recA—MN477251 | P. chlororaphis subsp. piscum JF3835T (FJ168539)—99.8% | * P. chlororaphis subsp. piscum ZJU60 (CP027656)—98.2%; P. chlororaphis subsp. aurefaciens NCIMB 9265 (AB039555)—98.2% | P. chlororaphis subsp. piscum JF3835T (FJ168540)—98.6% |
| MTB1 L3 12 | Serratia liquefaciens 16S rDNA—MM422010 rpoB—MN445052 | Serratia quinivorans DSM4597T (AJ233435)—99.4%; S. liquefaciens CIP 103238T (NR 042062)—98.9% | ** S. liquefaciens LMG7884T (JX425335)—99.4% S. quinivorans LMG7887T (JX425309)—97.7% | n.d. |
| MTA3 L2 13 | Acinetobacter calcoaceticus 16S rDNA—MN429316 rpoB—MN445056 | A. calcoaceticus DSM 30006T (AJ633632)—99.8% | ** A. calcoaceticus CIP 81.8T (DQ207474)—97.9%; A. calcoaceticus CA16 (NZ_CP020000)—98.7% | n.d. |
| MTS3 L3 15 | Pseudomonas chlororaphis 16S rDNA—MM421928 rpoD—MN445051 recA—MN477252 | P. chlororaphis subsp. piscum JF3835T (FJ168539)—99.7% | * P. chlororaphis subsp. piscum ZJU60 (CP027656)—98.4%; P. chlororaphis subsp. aurefaciens NCIMB 9265—98.4% | P. chlororaphis subsp. piscum JF3835T (FJ168540)—98.6% |
| MTC1 L3 03 | Serratia sp. 16S rDNA—MM422009 rpoB—MN445053 | Serratia grimesii DSM 30063T (AJ233430)—99.3%; Serratia proteamaculans DSM 4543T (AJ233434)—99.2% S. liquefaciens CIP 103238 (AJ306725)—99.1% | ** S. liquefaciens LMG7884T (JX425335)—98.8% S. quinivorans LMG7887T (JX425309)—98.3% | n.d. |
| MMH3 L2 04 | Chryseobacterium lathyri 16S rDNA—MM429317 rpoB—MN445063 | C. lathyri RBA2-6T (DQ673674)—99.8% | ** C. lathyri KCTCT 22544T (NZ_QNFY01000004)—99.1% | n.d. |
| MMH4 L2 06 | Chryseobacterium sp. 16S rDNA—MN429318 rpoB—MN445064 | C. nakagawai NCTC 13529T (NZLR134386)—98.7% | ** C. joostei DSM 16927T (CP033926)—93.6%; C. nakagawai NCTC 13529TT (LR134386)—91.0% | n.d. |
© 2020 by the authors. Licensee MDPI, Basel, Switzerland. This article is an open access article distributed under the terms and conditions of the Creative Commons Attribution (CC BY) license (http://creativecommons.org/licenses/by/4.0/).
Share and Cite
Skowronek, M.; Sajnaga, E.; Pleszczyńska, M.; Kazimierczak, W.; Lis, M.; Wiater, A. Bacteria from the Midgut of Common Cockchafer (Melolontha melolontha L.) Larvae Exhibiting Antagonistic Activity Against Bacterial Symbionts of Entomopathogenic Nematodes: Isolation and Molecular Identification. Int. J. Mol. Sci. 2020, 21, 580. https://doi.org/10.3390/ijms21020580
Skowronek M, Sajnaga E, Pleszczyńska M, Kazimierczak W, Lis M, Wiater A. Bacteria from the Midgut of Common Cockchafer (Melolontha melolontha L.) Larvae Exhibiting Antagonistic Activity Against Bacterial Symbionts of Entomopathogenic Nematodes: Isolation and Molecular Identification. International Journal of Molecular Sciences. 2020; 21(2):580. https://doi.org/10.3390/ijms21020580
Chicago/Turabian StyleSkowronek, Marcin, Ewa Sajnaga, Małgorzata Pleszczyńska, Waldemar Kazimierczak, Magdalena Lis, and Adrian Wiater. 2020. "Bacteria from the Midgut of Common Cockchafer (Melolontha melolontha L.) Larvae Exhibiting Antagonistic Activity Against Bacterial Symbionts of Entomopathogenic Nematodes: Isolation and Molecular Identification" International Journal of Molecular Sciences 21, no. 2: 580. https://doi.org/10.3390/ijms21020580
APA StyleSkowronek, M., Sajnaga, E., Pleszczyńska, M., Kazimierczak, W., Lis, M., & Wiater, A. (2020). Bacteria from the Midgut of Common Cockchafer (Melolontha melolontha L.) Larvae Exhibiting Antagonistic Activity Against Bacterial Symbionts of Entomopathogenic Nematodes: Isolation and Molecular Identification. International Journal of Molecular Sciences, 21(2), 580. https://doi.org/10.3390/ijms21020580

